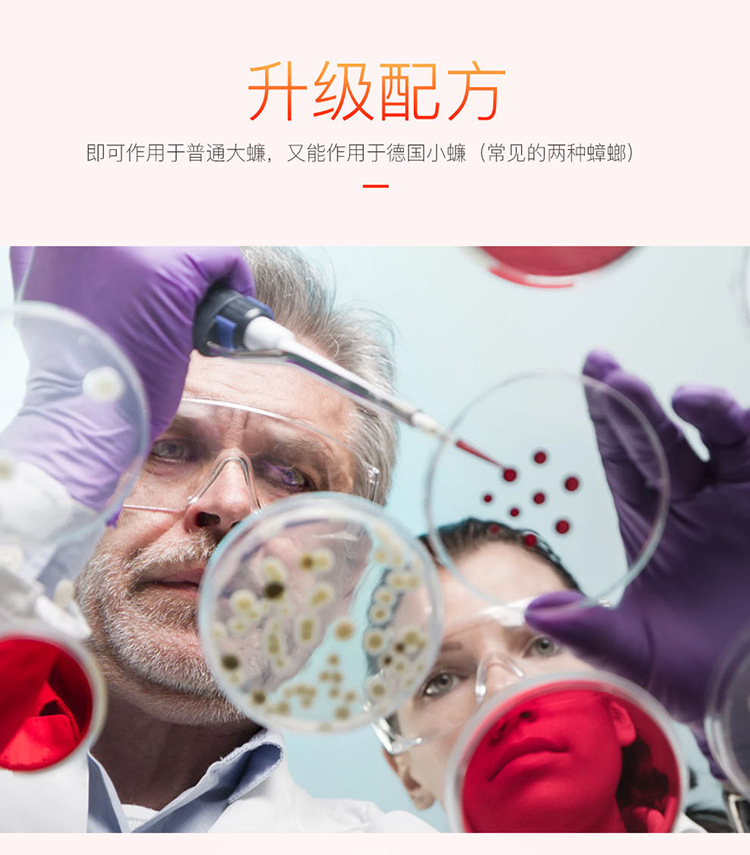
红蟑详情页_12.png

Search history
Clear allSearch by image
XDrag and drop an image here or upload an image
Max 5MB per image
UploadSign In | Join
X Email Mobile
Due to the fluctuating prices of product materials, please confirm the final purchase price before placing an order. If the product is ordered, we reserve the right to refuse to ship!
Due to the fluctuation of material prices, please consult the customer service in detail before placing an order~~ All products in our store do not include shipping, please consult the customer service in detail before placing an order!!!

Update time:
TOP